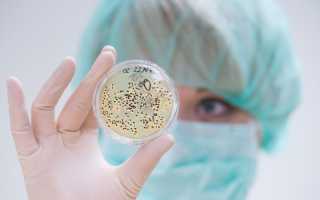

Жизнь вокруг нас устроена таким образом, что все в ней взаимосвязано. Исключение из общей цепочки одного звена повлечет за собой изменения в других составляющих. Поэтому, когда общее значение всех бактерий в жизни человека и природы называют огромным, значительным и неоценимым, это не просто громкие эпитеты. А раз существование микробов так важно, то стоит ознакомиться с их значением и влиянием.
Кто нас окружает
Для начала следует понять, с кем приходится иметь дело. Ведь и враги, и друзья часто настолько малы, что разглядеть их без микроскопа не представляется возможным. Строение бактерий достаточно простое:
- оболочка, нередко покрытая слоем слизи (для дальнейшего образования защитной капсулы);
- клеточная мембрана;
- неподвижная цитоплазма с рибосомами, различными включениями и молекулой ДНК, замкнутой в кольцо.
Иногда присутствуют жгутики, отвечающие за движение.
Несмотря на такое несложное строение, бактерии считаются одной из старейших форм жизни на Земле. Поражает и то, что видов у этих мельчайших организмов насчитывается достаточно много, чтобы оказывать влияние не только на человека.
Врачи подчеркивают, что бактерии играют ключевую роль как в жизни человека, так и в экосистемах природы. Эти микроорганизмы не только участвуют в пищеварении, помогая усваивать питательные вещества, но и поддерживают иммунную систему, защищая организм от патогенов. Врачи отмечают, что баланс микрофлоры в кишечнике важен для общего здоровья, а его нарушение может привести к различным заболеваниям.
Кроме того, бактерии выполняют незаменимую функцию в природе, участвуя в процессах разложения органических веществ и поддерживая круговорот питательных веществ в экосистемах. Они способствуют образованию почвы и очищению воды, что делает их важными для устойчивого развития окружающей среды. Таким образом, врачи акцентируют внимание на необходимости бережного отношения к микробиоме и экосистемам, подчеркивая их значимость для здоровья человека и планеты.

Микроорганизмы, которые мы «приручили»
Значение бактерий в человеческой жизни, которое оценивалось бы с положительной точки зрения, можно разделить на две группы:
- Поддержание жизнедеятельности организма на должном уровне.
- Помощь в пищевой, медицинской промышленности и некоторых других областях.
Внутри организма и на коже живет множество бактерий. Некоторые из них успешно помогают в пищеварении и выработке витаминов, служат защитой от других микробов, которые пытаются проникнуть извне с недружественными намерениями. К числу таких полезных для человека представителей царства прокариот относят кишечную палочку.
Больший вред, чем польза?
Наверное, с целью уравновесить значение бактерий в жизни человека, природа позаботилась о том, чтобы достаточное число представителей мельчайших организмов портило продукты и вызывало тяжелейшие заболевания. Причем строение позволяет им максимально долго выживать даже при самых изощренных способах обработки продуктов и предметов обихода человека.
Сальмонеллез, дизентерия, ботулизм, туберкулез, венерические заболевания – далеко не полный список неприятностей, которые сулит нам соседство с бактериями.
Опасаться стоит и других микроорганизмов. Например, вред для здоровья от жизнедеятельности некоторых грибков и простейших может быть значительным.
Бактерии играют ключевую роль в жизни человека и природы, и их значение трудно переоценить. Многие люди осознают, что эти микроскопические организмы участвуют в процессах пищеварения, помогая усваивать питательные вещества и синтезировать витамины. Однако их влияние выходит далеко за пределы человеческого организма. В природе бактерии участвуют в разложении органических веществ, что способствует восстановлению экосистем и поддержанию биогеохимических циклов.
Некоторые виды бактерий способны очищать загрязненные воды и почвы, что делает их незаменимыми в экологии. В сельском хозяйстве они помогают улучшать плодородие почвы, а в медицине используются для создания пробиотиков, которые укрепляют иммунную систему. Несмотря на то что некоторые бактерии могут вызывать болезни, большинство из них являются полезными и необходимыми для поддержания здоровья как человека, так и окружающей среды. Таким образом, бактерии — это не просто микробы, а важные союзники в нашем повседневном существовании.

Ничто не проходит бесследно
В природе ничего не происходит просто так. Если микроб получает питательные вещества из земли или растения, то он что-то отдает взамен или участвует в цепочке последовательных действий, которые играют важную роль для сохранения жизни. Так каково же значение бактерий в глобальном масштабе?
- Создание плодородного слоя почвы. Почвенные бактерии не единственные, кто трудится над этой задачей. Не обходится без помощи грибов. Строение и тех и других позволяет разлагать различные органические вещества, поступающие в землю, чтобы преобразовать их, в том числе и для собственного потребления. Человек тоже вносит свою лепту. Он рыхлит и удобряет почву, помогая не только культурным растениям, но и поддерживая тем самым жизнедеятельность грибов, простейших и бактерий.
- Переработка азота. Растениям крайне необходим этот элемент, но усваивать его из воздуха они не могут. Клубеньковые бактерии имеют строение, пригодное для выполнения этой работы. Взамен они получают нужные для себя питательные вещества.
- Санитарная функция. Бактерии способны очищать водоемы, впрочем, как и запускать обратный процесс.
Есть еще множество других процессов, которые подтверждают участие бактерий в круговороте веществ в природе.
Подводя итог в разговоре о значении бактерий, грибков и простейших микроорганизмов, нужно отметить, что однозначной оценки «хорошо» или «плохо» быть не может. Для человека и природы крайне важно, чтобы был соблюден определенный баланс, а развитие науки и собственных знаний поможет в его сохранении.
Вопрос-ответ

Какова роль бактерий в организме человека?
Бактерии в нашем организме помогают расщеплять пищу, которую мы едим, обеспечивают доступность питательных веществ и нейтрализуют токсины – вот лишь несколько примеров. Кроме того, они играют важную роль в защите от инфекций, защищая поверхности, на которых они обитают, от проникновения патогенов.
Какое значение имеет в природе в жизни человека?
Без природы его жизнь невозможна. Природа даёт нам всё, что необходимо для жизни: тепло, свет, воздух, воду, пищу, материалы для строительства, изготовления одежды, мебели и других изделий.
Советы
СОВЕТ №1
Изучайте микробиом своего организма. Понимание того, какие бактерии обитают в вашем кишечнике, может помочь вам улучшить здоровье. Рассмотрите возможность проведения тестов на микробиом и проконсультируйтесь с врачом о том, как поддерживать баланс полезных бактерий через питание и пробиотики.
СОВЕТ №2
Поддерживайте разнообразие в своем рационе. Употребление различных продуктов, особенно богатых клетчаткой, способствует росту полезных бактерий. Включайте в свое меню фрукты, овощи, орехи и цельнозерновые продукты, чтобы поддерживать здоровье кишечной флоры.
СОВЕТ №3
Не злоупотребляйте антибиотиками. Хотя они могут быть необходимы для лечения инфекций, чрезмерное использование антибиотиков может нарушить баланс бактерий в организме. Обсуждайте с врачом необходимость назначения антибиотиков и всегда следуйте его рекомендациям.
СОВЕТ №4
Участвуйте в охране окружающей среды. Бактерии играют важную роль в экосистемах, поэтому поддержка устойчивого развития и снижение загрязнения помогут сохранить разнообразие микробов в природе. Участвуйте в экологических инициативах и старайтесь минимизировать свой углеродный след.